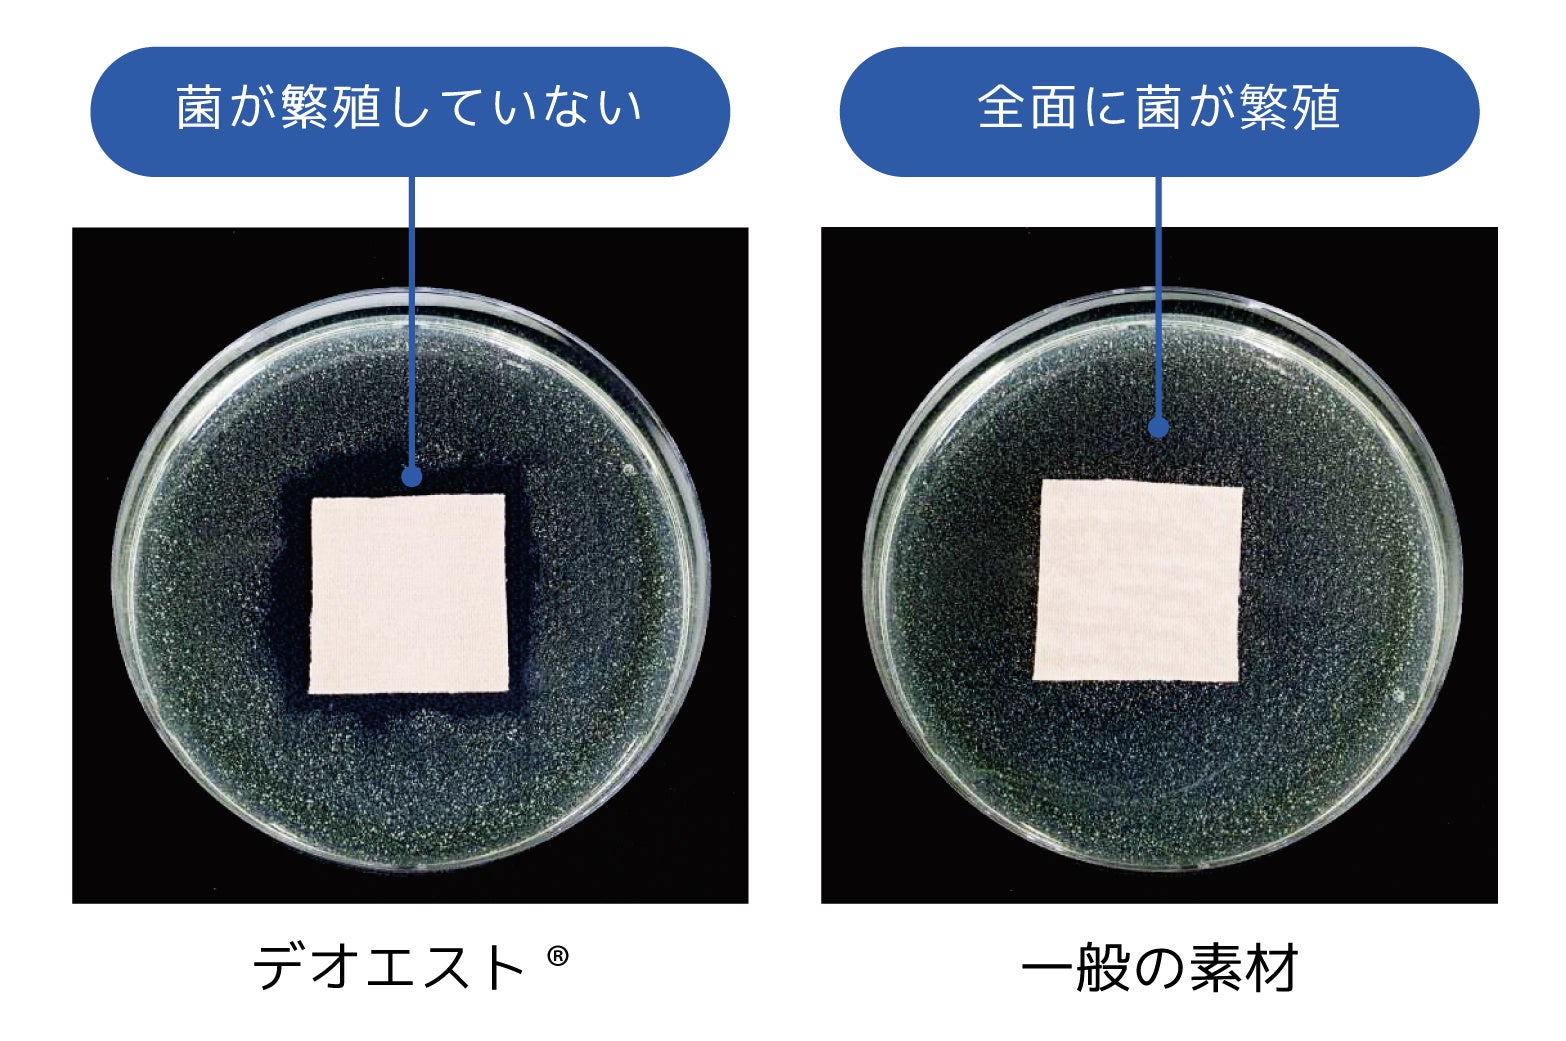

寒い季節ほど気になる体の「ニオイ対策」に!女性向け新作クルーネック、レギンス、タイツ発売!
消臭下着ブランドデオエストから2022秋冬向けの商品が登場!
総合繊維メーカーのセーレン株式会社(福井本社:福井県福井市、東京本社:東京都港区南青山/代表取締役会長 川田達男)は、着るだけで嫌なニオイを強力にシャットダウンする消臭アンダーウェア「デオエスト®️」から秋冬女性向け「消臭インナーWARM クルーネック」、「消臭レギンスWARM」、「消臭タイツ(綿混)」を10月25日より発売いたします。
販売サイト http://store.seiren.com/deoest/22aw_release_pr
販売サイト http://store.seiren.com/deoest/22aw_release_pr

これからの季節は汗の質が変わり、重ね着などの蒸れも気になります。体のニオイ成分が夏以上に強くなるといわれており、日頃のニオイ対策がより重要になります。
また、外出や移動、直接の商談や打ち合わせなど人と接する機会が増えており、今回発売の商品を効果的なニオイ対策としてお勧めします。
- 消臭インナークルーネック、消臭レギンス、消臭タイツの3商品が新登場!
ユーザーの声から誕生

消臭レギンス
ほどよい綿混の透け感

消臭タイツ
保温性も兼ね備える

- メンズは新色「ネイビー」「ダークグレー」を発売

ネイビー
黒に代わるベーシックカラーであり、知的で清潔感を自然に演出してくれるネイビー。
上品でシックな要素をプラスして好印象に。

ダークグレー
黒より主張を抑えてくれるダークグレーは、ニュートラルな印象を与える大人の色。都会的で落ち着いた雰囲気を演出するのに最適!
- 新商品詳細〈レディース〉


サイズ: M/L/LL
カラー:ブラック
生産国:日本
価格:3,872円(税込)
素材:
【本体】綿39%、レーヨン39%、ナイロン17%、ポリウレタン5%
【汗取りパッド】綿72%、ナイロン14%、ポリウレタン14%
販売サイト http://store.seiren.com/deoest/22aw_release_pr

WARM(10分丈)
サイズ:M/L/LL
カラー:ブラック
生産国:日本
価格:3,905円(税込)
素材:綿90%、ポリウレタン10%
販売サイト http://store.seiren.com/deoest/22aw_release_pr

サイズ:M-L/L-LL
カラー:ブラック
生産国:日本
価格:2,904円(税込)
素材:綿、ナイロン、ポリウレタン
販売サイト http://store.seiren.com/deoest/22aw_release_pr
- 新商品詳細〈メンズ〉

商品名: 消臭アンダーシャツWARM
サイズ : M/L/LLカラー : オフホワイト、ブラック、ダークグレー、ネイビー(NEW)
生産国 : 日本
価格 : 半袖:3,124円(税込) 8分袖:3,674円(税込)(※写真は8分袖です)
素材 : 綿90%、ポリウレタン10%
販売サイト http://store.seiren.com/deoest/22aw_release_pr

サイズ: M/L/LL
カラー: ダークグレー(NEW)、ブラック
生産国:日本
価格:3,674円(税込)
素材:綿90%、ポリウレタン10%
販売サイト http://store.seiren.com/deoest/22aw_release_pr
- 発売から10年 ユーザーから信頼される消臭メカニズム



- 洗濯後も抗菌機能が継続!

このプレスリリースには、メディア関係者向けの情報があります
メディアユーザーログイン既に登録済みの方はこちら
メディアユーザー登録を行うと、企業担当者の連絡先や、イベント・記者会見の情報など様々な特記情報を閲覧できます。※内容はプレスリリースにより異なります。
すべての画像
